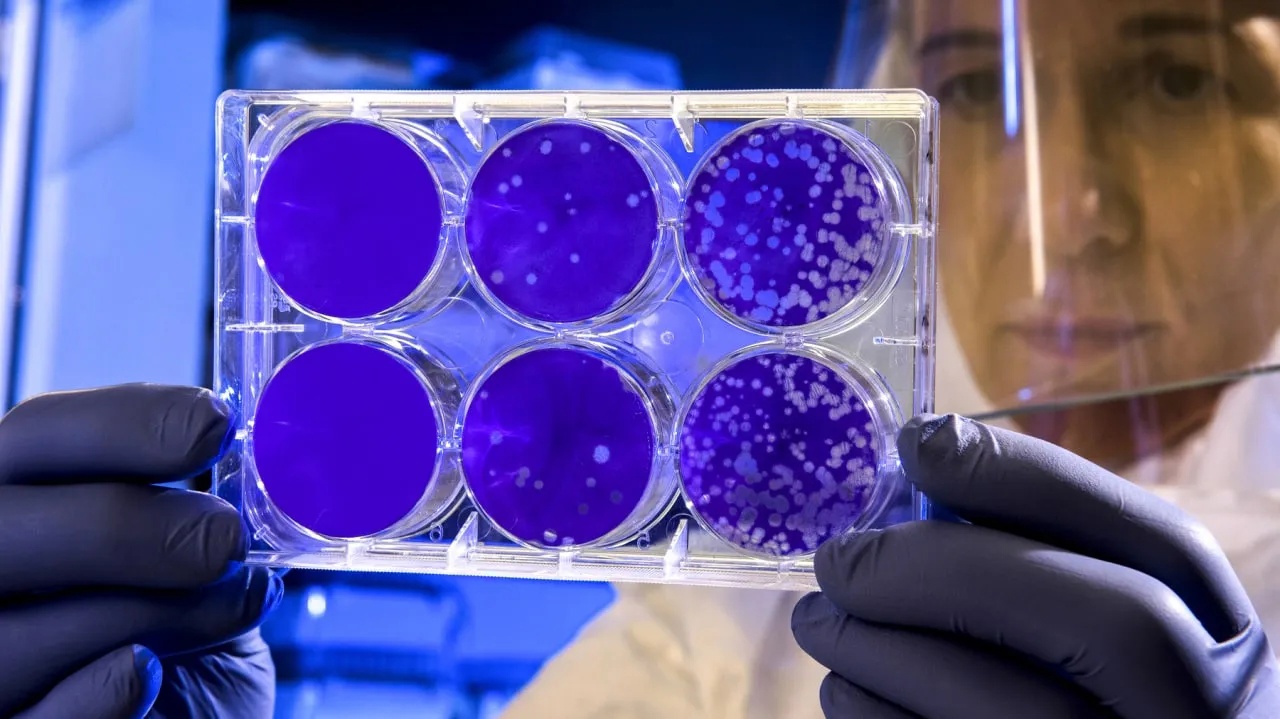
image

Наши новости

13.12.2022 в официальной группе управления здравоохранения Липецкой области в социальной сети «ВКонтакте» прошел прямой эфир из цикла «Отвечают врачи».
Грипп типа А (Н1N1), или «свиной грипп», это острое вирусное инфекционное заболевание. Люди очень восприимчивы к вирусу гриппа А (Н1N1), это приводит к быстрому росту числа заболевших, с высокой вероятностью развития пандемии. Свиной грипп отличается в большинстве случаев тяжелым течением с риском летальных исходов.

Продолжаем заниматься просветительской работой профилактической направленности. Врач-дерматовенеролог ГУЗ ОКВД Зеленова Мария Игоревна выступила в эфире телеканала "Липецкое время" и напомнила о такой важной проблеме, как инфекции, передаваемые половым путем. Полностью эфир можно посмотреть по ссылке

Знаете, когда лучше всего заниматься физкультурой? Оказывается, большинство олимпийских рекордов были установлены днем после полудня. Ученые считают, что время с 16 до 19 часов — самое эффективное для тренировок.

Врач -дерматоонколог, косметолог ГУЗ ОКВД Якушенко Сергей Сергеевич 1 декабря 2022г. выступает на XI Национальном Конгрессе «Пластическая хирургия, эстетическая медицина и косметология», который проходит в Москве. В Конгрессе принимают участие более 6000 пластических и челюстно-лицевых хирургов, оториноларингологов, фтальмохирургов, комбустиологов, травматологов-ортопедов, онкологов, гинекологов, урологов, неврологов, анестезиологов, дерматовенерологов и косметологов.

День учрежден с целью повышения осведомлённости об эпидемии СПИДа, вызванной распространением ВИЧ-инфекции, а также как день памяти жертв этого заболевания. Вирус иммунодефицита человека (ВИЧ) поражает иммунную систему и ослабляет защиту от многих инфекций и некоторых типов рака, с которыми может справиться иммунитет здорового человека. Вирус разрушает и ослабляет функцию иммунных клеток, поэтому у инфицированных людей постепенно развивается иммунодефицит

Сегодня мы хотим обратить ваше внимание на проблему Акне (угревой болезни). В основе заболевания лежит воспаление сальной железы из-за активной продукции кожного секрета. Провоцирующими факторами, как правило, являются гормональные изменения в организме. Этим можно объяснить то, что угри чаще всего встречаются у подростков, беременных, у девушек и женщин в последние 7 дней менструального цикла, а также у людей, принимающих гормональные препараты

С 23 ноября по 04 декабря 2022 года на базе ГУЗ «Липецкий областной Центр по профилактике и борьбе со СПИД и инфекционными заболеваниями» будет открыта горячая телефонная линия
«БОЯТЬСЯ НЕ НАДО, НАДО ЗНАТЬ!»
где каждый желающий сможет задать интересующий его вопрос о ВИЧ-инфекции, мерах личной профилактики.
Достоверная информация, полученная от специалиста, поможет развеять сомнения и избежать ненужных страхов.

